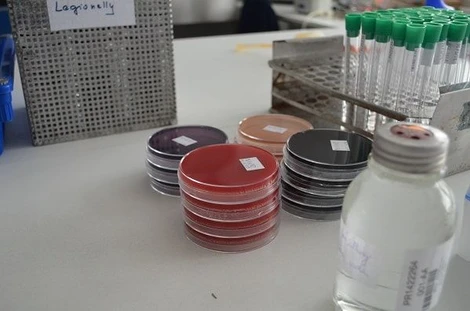
Patogenní mikroorganismy a Listeria monocytogenes

Rozcestník
Další informace
WebinářeO násKontaktujte násPodmínky užití
LabRulez s.r.o. Všechna práva vyhrazena. Obsah dostupný pod licencí CC BY-SA 4.0 Uveďte původ-Zachovejte licenci.

Článek | Webináře
Prosincové webináře: Vzorkování a vzorkovnice jsou naším klíčem k přesné environmentální analýze
Naši dva odborníci, Pavel Zbirovský a Ivan Trešl, Vám představí, jak správně přistupovat k odběru vzorků, jaké metody a nástroje používat a proč je kvalitní vzorkování zásadní.
Po, 2.12.2024
ALS Czech Republic


Článek | Produkt
EnviroMail™15/Evropa: Stanovení steroidních hormonů ve vodě
Mikropolutanty se do vody dostávají nejčastěji z přípravků na ochranu rostlin v zemědělství, ale čím dál častěji také z léčiv a veterinárních farmak, a v nemalé míře také z tzv. produktů osobní péče.
Čt, 4.4.2024
ALS Czech Republic

Další informace
WebinářeO násKontaktujte násPodmínky užití
LabRulez s.r.o. Všechna práva vyhrazena. Obsah dostupný pod licencí CC BY-SA 4.0 Uveďte původ-Zachovejte licenci.